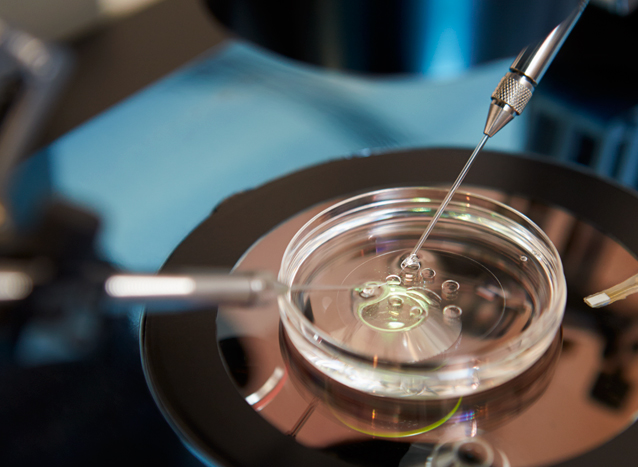

Life Fertility Clinic located in Brisbane and Sydney specialises in all aspects of fertility and family creation. Whether you’re new to all of this or have already been through treatments unsuccessfully, our approach will give you the best care and the best chances.
When you’re dealing with something as close to your heart as creating a family it’s vital to get the very best advice. Unlike some production-line approaches, we do thorough testing up-front often saving you months of heartache and expensive, unproductive cycles of treatment. We find the shortest pathway to the greatest joy.
Different paths to creating families